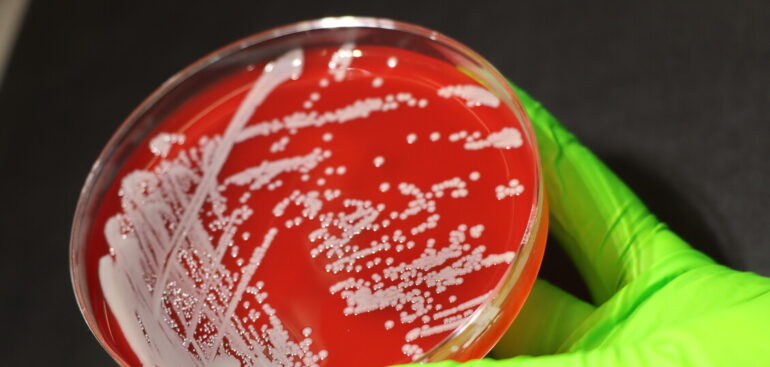

Esperti,garantire accesso a screening annuale con controllo nei
In pazienti non diabetici. Ascierto, dieta può influenzare cure
Ogni anno 15mila casi, fondamentale la diagnosi precoce
Al Pascale trattato primo paziente di uno studio internazionale
Ascierto, il 50% dei pazienti metastatici sopravvive a 10 anni dalla diagnosi
Con nivolumab più ipilimumab. Dieci anni fa il tasso di sopravvivenza era al 25% dopo un anno
Grazie alla combinazione con una molecola.
Sarah Ferguson, 64 anni, ex moglie del principe Andrea e madre della principessa Beatrice e della principessa Eugenia, ha ricevuto la diagnosi di un cancro maligno della pelle, scoperto mentre era in cura per un tumore al seno. Il melanoma è stato scoperto dopo che diversi nei sono stati rimossi in […]
Prevengono il tumore e potenziano l’effetto dell’immunoterapia
Da “ultima spiaggia” a terapia di prima scelta. Nel giro di pochissimi anni l’immunoterapia ha fatto un enorme salto di qualità tanto che oggi i clinici chiedono di estendere il ricorso ai cosiddetti inibitori dei checkpoint immunitari anche per la terapia neoadiuvante, cioè al trattamento prima dell’intervento chirurgico. Ci sono infatti […]